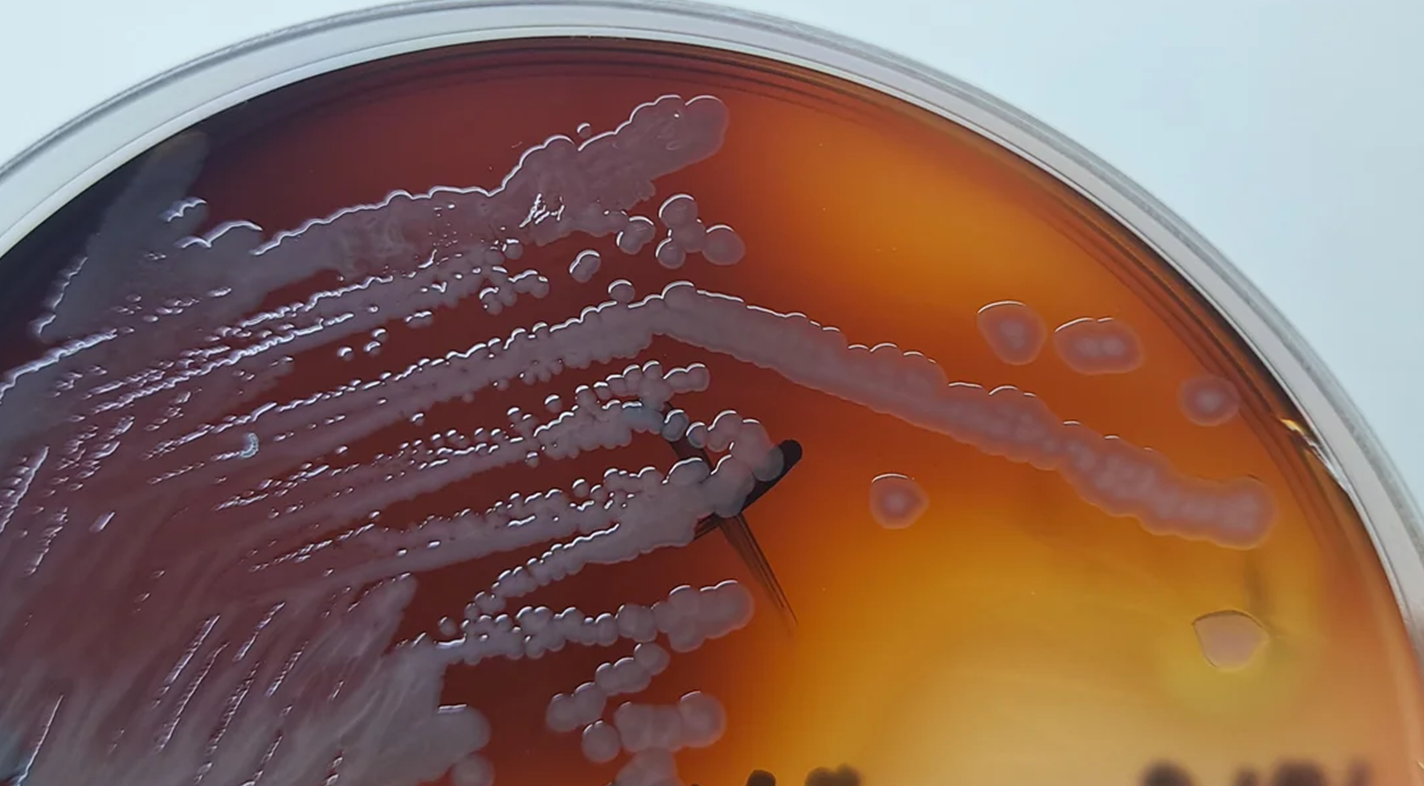
Культура Pseudomonas aeruginosa, выделяющая пиомеланин

Меланин — универсальный черный
17 февраля 2026
Меланин — универсальный черный
- 947
- 0
- 2
Примеры меланиновой окраски в живой природе. По часовой стрелке, начиная с правого верхнего угла: соцветие подсолнечника, наполненное созревшими семенами; глаз козы с коричневой радужкой; конидии плесневого гриба Aspergillus niger; черный экзоскелет жука.
Рисунок в полном размере.
коллаж на основе latifundist.com, unsplash.com, jardineriaon.com, paulmunnsinstantlawn.com
-
Автор
-
Редакторы
Статья на конкурс «Био/Мол/Текст»: Меланины — это семейство темных полимерных пигментов, которые широко распространены в живой природе. В своих клетках их накапливают самые разные организмы с разными условиями жизни: грибы, бактерии, растения и животные. Каким же функционалом должен обладать пигмент, чтобы приносить пользу всем им? Дело в том, что меланин — это своеобразный мультитул. И фотопротективные свойства, благодаря которым он известен, — это только одна из его функций. Из этой статьи вы узнаете, на что еще способен меланин и какие секреты строения делают его настолько универсальным.
Конкурс «Био/Мол/Текст»-2025/2026
 Эта статья участвовала в конкурсе «Био/Мол/Текст»-2025/2026 в номинации «Свободная тема» и будет опубликована в журнале «Наука и жизнь».
Эта статья участвовала в конкурсе «Био/Мол/Текст»-2025/2026 в номинации «Свободная тема» и будет опубликована в журнале «Наука и жизнь».

Генеральный партнер конкурса — международная инновационная биотехнологическая компания BIOCAD.

Партнер номинации — компания SkyGen: передовой дистрибьютор продукции для life science на российском рынке.

«Книжный» спонсор конкурса — «Альпина нон-фикшн»
Разнообразие
Меланины животных (в том числе человека) традиционно делят на два основных типа: эумеланин (от греч. eû — хороший, настоящий) — отвечает за черно-коричневую окраску тканей — и феомеланин (от греч. phaiós — темный) — отвечает за желтовато-красные оттенки. Позднее были открыты еще два типа меланина, они получили свои названия по источнику выделения: нейромеланин (обнаруженный в определенных участках мозга человека и других приматов) и пиомеланин (от греч. púon — гной), синтезируемый некоторыми болезнетворными микроорганизмами. Остальные меланины, выделенные из растений, грибов и бактерий, объединили под названием алломеланины (от греч. állos — другой) [1]. Все пять типов меланина отличаются по химическим и физическим свойствам.
К сожалению, источник выделения пигмента не всегда может помочь в его классификации, ведь многие организмы способны к синтезу сразу нескольких типов меланина. Для того, чтобы разобраться в различиях, полезнее рассмотреть их химические структуры.
Синтез любого вещества начинается с субстрата. В случае меланина главным субстратом у многих организмов выступает аминокислота L-тирозин (рис. 1). Из нее в два этапа фермент тирозиназа (или его аналоги у других организмов) образует ДОФА-хинон. Он очень реакционноспособен, поэтому легко преобразуется в основной прекурсор меланина — 5,6-дигидроксииндол (DHI). Такой путь синтеза могут использовать все: животные, бактерии, грибы и растения [2–4]. Модифицируя отдельные этапы синтеза, организмы научились производить отдельные типы меланина — каждый со своими химическими особенностями.

Рисунок 1. Упрощенные пути биосинтеза меланинов животных, растений, грибов и бактерий из тирозина. В прямоугольниках показаны структуры и названия основных прекурсоров для каждого типа меланина. Рядом дан список организмов, которые предположительно способны его синтезировать. Между тирозином и ДОФА-хиноном — список ферментов, способных осуществлять это превращение у разных организмов.
Эумеланин и феомеланин
Помимо обычной тирозиназы, в меланоцитах млекопитающих был обнаружен дополнительный фермент, названный TYRP-2, или ДОФА-хром таутомераза. С его помощью возможен синтез еще одного прекурсора меланина — 5,6-дигидроксииндол-2 карбоновой кислоты (DHICA) [2]. Таким образом, в состав эумеланина входят сразу два типа мономеров — остатки DHI и DHICA.
Феомеланин синтезируется из того же ДОФА-хинона, только в процессе к нему присоединяется аминокислота цистеин. Так как цистеин содержит в своем составе атом серы, характерной чертой феомеланина является ее высокое содержание — около 6–16% по сравнению с 0,2 % в эумеланине [5].
Пути синтеза эу- и феомеланина очень схожи, и часто они синтезируются совместно. Чисто эумеланиновую или феомеланиновую окраску в живой природе найти сложно, почти всегда это результат комбинации обоих пигментов [3].
Нейромеланин
Нейромеланин, в отличие от меланинов кожи, синтезируется в нейронах. В том числе, он придает цвет участку мозга, названному черной субстанцией. Его основные прекурсоры — нейромедиаторы группы катехоламинов: дофамин и, в меньшей степени, норадреналин. По аналогии с синтезом феомеланина, в процессе к ним могут присоединяться остатки цистеина. Когда цистеин в нейроне заканчивается, синтез продолжается без него. Так формируется своеобразная двойная структура гранул нейромеланина — феомеланиновое ядро, покрытое эумеланиновой оболочкой (рис. 2) [1], [5], [6].

Рисунок 2. Схема образования двуслойной структуры гранул нейромеланина в процессе смешанного меланогенеза. Сначала, в присутствии цистеина, синтезируется феомеланин и образует феомеланиновое ядро. Затем оно покрывается оболочкой из эумеланина. Гранула, покрытая эумеланином, на рисунке показана в разрезе.
ДХ — ДОФА-хинон, ДХА — дофамин-хинон.
Пиомеланин
Пиомеланин (рис. 3) синтезируют в основном бактерии, разрушая для этого ароматические аминокислоты — тирозин или фенилаланин. Из тирозина в результате образуется гомогентизиновая кислота (HGA). Ее присутствие отличает пиомеланин от других типов меланина [5].
Пиомеланин могут синтезировать в том числе Legionella pneumophila (возбудитель «болезни легионеров» — формы пневмонии) и Burkholderia cepacia (исключительно устойчивый патоген, преимущественно вызывает пневмонию у людей с иммунодефицитом).
Рисунок 3. Культура Pseudomonas aeruginosa, выделяющая пиомеланин.
Алломеланины
Алломеланины стоят особняком от предыдущих типов, потому что для их синтеза не используется L-тирозин. Вместо него бактерии, грибы и растения используют другие доступные метаболиты: ацетат, малонил-КоА и катехолы, соответственно (рис. 4).
Слегка отличаются и ферменты, необходимые для синтеза. Полифенолоксидаза растений уже появлялась на предыдущей схеме – она по сути является аналогом тирозиназы животных, но способна окислять широких спектр фенольных соединений. А бактерии и грибы используют ферменты поликетидсинтазы, что позволяет им преобразовывать субстраты, вообще не содержащие бензольных колец [2].
Если внимательно посмотреть на субстрат и основные прекурсоры алломеланинов, можно заметить еще одну особенность — в них совсем нет азота. В целом полимере его меньше 2%. Считается, что так организмы, живущие в условиях недостатка азота (в частности, растения), стремятся его экономить [1].

Рисунок 4. Упрощенные пути биосинтеза алломеланинов из субстратов, отличных от тирозина. В прямоугольниках показаны структуры и названия основных прекурсоров для каждого типа меланина. Под названием типа меланина указаны организмы, которые предположительно способны его синтезировать. Рядом со стрелками приведены названия ключевых ферментов, участвующих в синтезе. Полифенолоксидаза растений действует аналогично тирозиназе животных. Поликетидсинтазы синтезируют поликетиды, которые после циклизации и образуют бензольные кольца.
Итак, с мономерами мы разобрались. Что происходит дальше? Мономеры соединяются друг с другом и формируют одну длинную молекулу — полимер.
Синтез полимера

Рисунок 5. Основные уровни неупорядоченности меланина. Белыми блоками обозначены процессы, обеспечивающие неупорядоченность на различных стадиях полимеризации. Желтыми блоками, примыкающими к белым, — название соответствующей неупорядоченности.
Изучение структуры меланина на уровне полимера — это уже задача со звездочкой. Дело в том, что меланин аморфен, не растворяется в большинстве растворителей и устойчив к химической деградации. Растворить его способна жесткая щелочь, но в большинстве случаев это означает разрушение сразу до мономеров, так что восстановить оригинальную структуру все равно невозможно. Еще меланин часто прочно связан с клеточными тканями (например, клеточной стенкой), поэтому белки и липиды, оставшиеся от нее после растворения, могут мешать анализу [7].
Но, тем не менее, кое-что ученым все-таки удалось понять.
В отличие от таких известных биополимеров, как ДНК и белки, меланин химически крайне неупорядочен и состоит из целого набора разных по свойствам строительных блоков [8]. Причем эта неупорядоченность проявляется на всех уровнях строения (рис. 5).
Первый уровень – разнообразие мономеров. Помимо «образцовых» мономеров, которые мы уже рассмотрели, в состав меланина в небольшом количестве могут включаться остатки L-тирозина, ДОФА-хинона и других хинонов, части пептидов или белков и ионы некоторых металлов. В общем практически все, что попадется под руку [1].
В процессе полимеризации классические мономеры меланина — DHI и DHICA — могут связываться друг с другом, образуя димеры (рис. 6А, 6Б) или тетрамеры (рис. 6В) — с порфириновым кольцом внутри [8–11].
Тетрамеры, в свою очередь, агрегируют и организовываются в «слоеные» стопки, напоминающие стопки блинчиков (рис. 7А). Стопки могут различаться по размеру и близости друг к другу соседних молекул (рис. 7Б), а это вносит в систему еще два уровня неупорядоченности [10].
Полимеризация меланина проходит в три стадии:
Первая — быстрое образование меланохромов — хромофоров меланина, интенсивно поглощающих свет. Меланохромы образуются за счет окисления и объединения мономеров в олигомеры — те самые стопки блинчиков.
Когда окисляться больше нечему, начинается вторая стадия — более медленная. Во время нее молекула реорганизует свою внутреннюю структуру. Связи между мономерами становятся стабильнее, а электроны получают возможность путешествовать по всему объему полимера. За счет этого отдельные меланохромы начинают сообщаться друг с другом, а их спектры поглощения объединяются в один широкий спектр, характерный для меланина.
На третьей стадии полимер максимально уплотняется и становится твердым и нерастворимым в воде. Такое состояние очень стабильно [8].
Итак, все характерные для меланина свойства — химическая стабильность, нерастворимость и аморфность, которые мешали исследовать его — прямое следствие его структуры. Меланин — это набор молекул-хромофоров с разными свойствами, но объединенных в систему. За счет сочетания всех их свойств готовый полимер получается исключительно устойчивым к внешним воздействиям.
Наконец, полимеризованный меланин агрегирует, образуя наночастицы — шарики размером 100–200 нм (рис. 8) [12].
Меланосомы и меланоциты
Еще одна особенность синтеза меланина — токсичные интермедиаты, способные вызвать повреждения в клетках. Чтобы этого избежать, бактерии и грибы синтезируют меланин в вакуолях, а затем «выбрасывают» его за клеточную стенку. Пигмент прочно связывается с ней и образует щит. Так как слой меланина располагается снаружи клетки, ни с чем внутри он не взаимодействует [3].
А у животных синтез меланина обычно проходит в специальных органеллах — меланосомах (рис. 9). И занимаются им специализированные клетки — меланоциты. Про них мы еще поговорим в последней главе.

Рисунок 9. Стадии синтеза фео- и эумеланосом. На стадиях I и II от клеточной мембраны меланоцита отделяется везикула, в накапливается белок. В феомеланосомах этот белок остается аморфным, а в эумеланосомах приобретает форму белковых нитей. Они формируют «строительные леса» для последующего отложения пигмента. На стадиях III и IV происходит синтез меланина, а меланосомы приобретают цвет.
Когда меланосомы полностью готовы, меланоциты транспортируют их в кератиноциты кожи, волос и перьев. Там они и будут выполнять свои функции, пока не разрушатся. Передача меланосом — единственный известный пример перемещения целых органелл между клетками [3].
Фотопротекция
Ультрафиолетовое излучение, главным источником которого для нас является Солнце, при попадании на живые ткани способно вызывать повреждение ДНК, белков и целых клеточных структур. Оно может превращать молекулы внутри клетки в свободные радикалы — высокореактивные и токсичные частицы, которые приводят к вторичному повреждению [13].
Когда кожа человека подвергается действию УФ-излучения, в ней активизируется синтез меланина [3]. Считается, что именно меланин помогает защитить нежные клетки кожи от повреждения высокоэнергетическими фотонами. Но почему обычный пигмент на это способен?
На самом деле, меланин обладает не совсем «обычными» для биологического пигмента свойствами. Он имеет один из самых высоких среди биологических материалов показатель преломления — примерно 1,8—2,0. (Для сравнения, показатель преломления костной ткани, одной из самых плотных в нашем теле, составляет около 1,4–1,65 [14]).
То есть уже на этапе попадания волны света на гранулу меланина часть ее отражается обратно — около 8–11 %. Оставшаяся волна, прошедшая внутрь, замедляется, теряя около половины своей скорости [12]. Так у меланина появляется больше времени на взаимодействие с ней — ослабление и поглощение.
Спектр поглощения у меланина тоже необычный. Он очень широкий — включает весь диапазон от дальнего ультрафиолета (УФ-С) до ближнего инфракрасного света (ИК) и не содержит выраженных пиков, характерных для отдельных хромофоров (рис. 10). Способность к поглощению фотонов у меланина просто плавно увеличивается по мере увеличения их энергии. В результате наиболее эффективно меланин поглощает именно высокоэнергетические УФ-фотоны (длина волны 200–300 нм) [5], обеспечивая защиту клетки от их повреждающего действия [15].

Рисунок 10. Спектр поглощения меланина для раствора концентрацией 0,4 г/л (экспоненциальная аппроксимация первого порядка). Линиями внутри обозначены спектры хромофоров, из которых мог сложиться общих спектр. УФ-С — дальний ультрафиолет (100–280 нм), УФ-В — средний ультрафиолет (280–315 нм), УФ-А — ближний ультрафиолет (315–400 нм), ИК — инфракрасный свет (800 нм—1 мм).
Секрет этого спектра кроется в исключительной химической и геометрической гетерогенности молекул меланина. В их состав входят разные хромофоры, способные к поглощению на разных длинах волн. Суперпозиция их спектров и создает плавную кривую без пиков. Более того, электромагнитное взаимодействие между соседними хромофорами может приводить к образованию общих экситонных состояний с новыми свойствами — например, усиленным поглощением в УФ области [13].
Способность к флуоресценции у меланина очень слабая: ее квантовый выход (то есть доля поглощенных фотонов, которая излучается обратно) составляет меньше 0,1%. Значит, энергия остальных поглощенных фотонов должна рассеиваться другими путями, не требующими излучения [13].
С помощью исследований, комбинирующих сразу несколько методов спектроскопии, эти пути удалось выяснить для эумеланина — самого распространенного типа меланина у животных.
Итак, процесс рассеяния энергии внутри проходит в два этапа (рис. 11).

Рисунок 11. Схематическое представление двухшаговой модели релаксации эумеланина. Сначала ультрабыстрое (100 фс или 10-13 c) преобразование энергии среди локальных связанных экситонных состояний обеспечивает более низкоэнергетическое распределение возбуждения. Затем возбужденный протон переносится в растворитель (4 пс или 4*10-12 c).
Когда высокоэнергетический фотон попадет на ансамбль связанных друг с другом хромофоров меланина, его энергия «растекается» по нему, занимая более низкие энергетические уровни, соответствующие видимой части спектра. Этот процесс происходит практически мгновенно. За счет потерь до половины энергии УФ-фотона может рассеяться в виде тепла уже на первом этапе. Возбужденное состояние хромофоров быстро локализуется, и вся энергия оказывается «заперта» в области размером около 2 нм (помним, что размер наночастицы меланина — от 100 до 200 нм).
Затем все возбужденные молекулы хромофоров возвращаются обратно в основное состояние, а оставшаяся энергия превращается в безвредное тепло. Похоже, что мономер DHICA (на схеме выделен желтым), может играть на втором этапе не последнюю роль. На эту мысль исследователей натолкнула удивительная схожесть динамики возбуждения одной молекулы DHICA и динамики возбуждения всего меланина.
Когда молекула DHICA переходит в возбужденное состояние, резко возрастает ее кислотность. Протон одной из фенольных групп может легко отрываться от молекулы и переходить в раствор. Новая конфигурация создает удобный безызлучательный путь, позволяющий молекуле рассеять энергию и вернуться обратно в основное состояние. Энергия преобразуется в тепло, а протон возвращается обратно к DHICA [13].
Энергия УФ-излучения поглощается и рассеивается меланином так быстро, что оно просто не успевает нанести клетке какие-либо повреждения.
Но даже если парочка фотонов все-таки ускользнула, и в клетке образовались свободные радикалы — молекулы меланина способны их нейтрализовать [5]. Меланин химически инертен, и если свободный радикал вступит с ним в реакцию, то полученный меланином лишний заряд просто распределится среди множества химических связей и больше не передастся.
Так меланин обеспечивает защиту не только от первичного повреждения самим УФ-излучением, но и от вторичных последствий — повреждения свободными радикалами.
Радиация и черные грибы
Еще более высокоэнергетическим, чем ультрафиолет, является рентгеновское (Х-лучи) и гамма-излучение. Оба относятся к ионизирующему излучению (радиации), то есть способному «выбивать» электроны из атомов, превращая их в ионы. Как и в случае ультрафиолета, попадание ионизирующего излучения на живые клетки приводит к возникновению в них цитотоксических молекул — свободных радикалов.
У микроскопических грибов вроде Cryptococcus neoformans с радиацией особые отношения. Они спокойно растут в местах с мощным радиационным фоном — на космических станциях, в горах Антарктики и даже на стенах разрушенного реактора Чернобыльской АЭС [16]. А еще эти грибы — черные.
Клетки C. neoformans снаружи окружены щитом в виде концентрических слоев меланина. Даже после растворения в сильной кислоте они сохраняют свою форму, оставляя после себя «меланиновый призрак» (рис. 12) [17].

Рисунок 12. Меланизированный Cryptococcus neoformans и «меланиновые призраки». (а) — меланизированный C. neoformans в суспензии туши для иллюстрации местонахождения меланина в клетке. Клеточная стенка кажется темной из-за присутствия меланина. Обратите внимание, что меланин находится с внешней стороны от тела клетки. (б) — меланиновые призраки, изготовленные из меланизированных клеток C. neoformans с помощью обработки сильной кислотой, которая растворяет все клеточные компоненты, кроме меланина, ассоциированного с клеточной стенкой. (в) — электронная микрофотография меланинового призрака, показывающая гранулированную структуру его поверхности, ее пористость и толщину.
Организованный таким образом меланин способен физически защищать клетки от ионизирующего излучения. Суспензия меланиновых призраков ослабляет рентгеновское излучение на 40%. Это всего в два раза хуже, чем алюминиевая фольга — плотный материал. Помимо этого, меланин может захватывать и нейтрализовать свободные радикалы, смягчая и косвенный вред, который может быть нанесен ионизирующим излучением [18].
Однако меланизированные грибы способны не только избегать разрушительного действия радиации, но и извлекать из него пользу. Эффект, названный радиотропизмом, был впервые замечен у видов микроскопических грибов, населяющих разрушенный ядерный реактор Чернобыльской АЭС. Они мигрировали в сторону обломков, содержащих радиоактивные горячие частицы, и вызывали их деградацию. В последующих экспериментах на неокрашенных и меланизированных линиях грибов выяснилось, что последние не только лучше переносили гамма-излучение, но даже ускоряли свой рост под его воздействием [16], [17]. Так возникла идея о том, что грибы могут быть способны к захвату и преобразованию ионизирующего излучения в биодоступную энергию [16].
Этот феномен получил название радиосинтеза — по аналогии с фотосинтезом растений. Только в случае грибов в качестве источника энергии используется не видимый свет, а ионизирующее излучение [17].
Способность меланина в принципе взаимодействовать с ионизирующим излучением можно предположить, исходя из результатов некоторых наблюдений. Например, после радиационного облучения у меланина изменяются электронные свойства, в частности спектры электронного парамагнитного резонанса. Также в исследованиях in vitro было показано, что облученный радиацией меланин способен восстанавливать NAD — основной переносчик электронов в клетке — до NADH. Так может обеспечиваться необходимая связь, через которую электромагнитная энергия переводится в биологически доступную химическую энергию [17].
Но фотосинтез, помимо использования энергии солнечного излучения, подразумевает и сложную систему химических реакций, приводящих к собственно синтезу новых молекул. Поэтому аналогия между радиосинтезом и фотосинтезом может быть проведена только частичная. Хотя и существуют предположения, что грибы способны использовать CO2 в качестве источника углерода для синтеза новых молекул, достаточного подтверждения они пока не получили [17].
Похоже, что, в отличие от фотосинтеза растений, радиосинтез грибов может быть для них лишь дополнительным источником энергии. Тем не менее, само его свидетельство — уникальный пример того, что жизнь всегда найдет путь, даже в зараженных радиацией реакторах Чернобыля.
Вирулентность и иммунитет
Меланин обеспечивает живым организмам замечательную защиту от повреждающих факторов окружающей среды. Разумеется, с помощью меланина можно защищаться и друг от друга.
Меланизация клеток ассоциирована с повышенной вирулентностью некоторых патогенных грибов, включая C. neoformans (у человека вызывает криптококкоз) и E. dermatitidis (распространенный возбудитель феогифомикоза), по сравнению с немеланизированными вариантами этих грибов [19].
Слой меланина защищает их и от оксидантов, которые выделяют нейтрофилы, и от дефензинов и других микробицидных пептидов фагоцитов. Эти вещества связываются меланином и уже не могут проникнуть непосредственно к клетке гриба. Тот же механизм действует и в случае некоторых противогрибковых антибиотиков, например, амфотерицина B и каспофунгина. Меланизированные грибы реже фагоцитируются иммунными клетками, предположительно за счет измененной гидрофобности и заряда клетки (рис. 13) [19].

Рисунок 13. Меланин в клеточной стенке защищает патогенные грибы от повреждающих факторов. Меланизированные клетки C. neoformans менее чувствительны к различным потенциально летальным воздействиям. Считается, что меланин клеточной стенки формирует физический барьер между окружающей средой и клеточной мембраной.
Еще меланин может связывать кальций, не давая клеткам гриба построить толстую полисахаридную капсулу. В результате остатки этих полисахаридов накапливаются в тканях хозяина, нарушая секрецию провоспалительных цитокинов и снижая пролиферацию Т-клеток (рис. 14) [20].

Рисунок 14. Модель кальций-зависимой сборки внешней полисахаридной капсулы. И немелазированные (слева), и меланизированные (справа) клетки формируют плотную внутреннюю капсулу. Однако рост кальций-зависимой внешней капсулы, нормально проходящий в немеланизированных клетках, нарушен в меланизированных из-за связывания кальция с меланином.
Тем не менее, меланин — оружие универсальное, поэтому им пользуются не только патогены, но и организмы, которые с ними борются. Например, меланин является важной частью иммунитета насекомых.
При проникновении внутрь тела насекомого патогена его патоген-ассоциированные молекулярные паттерны (PAMP) опознают специальные рецепторы, находящиеся в гемолимфе. Они передают сигнал другим клеткам, что приводит к запуску каскада, который активирует ферменты фенолоксидазы (ФО). Специализированные гемоциты выпускают фермент в нужном месте, и он начинает синтезировать меланин, который обволакивает патоген, обездвиживая и склеивая его, а также перекрывая доступ кислорода [21].
Из-за того, что синтез меланина приводит к высвобождению токсичных интермедиатов, насекомые вынуждены его ограничивать. Интересно, что для этого они используют протеиновые фибриллы — как и позвоночные животные. Они действуют как «строительные леса», концентрируя и упорядочивая предшественники меланина, что ускоряет его полимеризацию. Так меланин эффективно обезвреживает проникшие в рану патогены, не вредя при этом организму самого насекомого [21].
Изначальный барьер — плотная экзокутикула насекомых — тоже образуется с участием меланина. Уже знакомый нам L-тирозин преобразуется в L-ДОФА и дофамин. Дофамин независимо метаболизируется лакказами в бесцветный дегидро-N-ацетилдофамин и бурый дегидро-N-β-аланилдофамин. Эти полимеры «склеивают» новую экзокутикулу вместе. Образованный через параллельный путь синтеза DHI-меланин включается на последних стадиях склеротизации, прочно связываясь с белками (например, склеротином) [21].
Похожий механизм иммунной защиты обнаруживается, внезапно, и у растений (рис. 15) [22].

Рисунок 15. Меланин участвует в иммунном ответе и у насекомых, и у растений. Слева — личинка моли Galleria mellonella, зараженная патогенным грибом Candida auris. Внутри тела личинки видны черные скопления — меланизированные агрегаты C. auris. Справа — надкушенное яблоко, на поврежденных тканях видны потемнения, обусловленные накоплением меланина.
В их случае этот процесс называется ферментативным потемнением. Он запускается, когда ткани растения повреждаются (патогенами, травоядными животными или из-за других факторов). Представьте, например, что вы откусили яблоко. Это вызвало разрушение клеток и нарушение целостности клеточных мембран. Фермент полифенолоксидаза высвобождается из хлоропластов, в которые он был заключен, и реагирует со своим субстратом, хранящимся в вакуолях. Если ненадолго оставить надкушенное яблоко на воздухе, можно увидеть результат их реакции — потемнение. Используя кислород воздуха, полифенолоксидаза окисляет фенольный субстрат, приводя к образованию меланина на поверхности поврежденной ткани [23]. Меланин, в свою очередь, призван предотвращать распространение патогена и снижать пищевую ценность тканей растения для поедающего его животного [24].
Итак, меланин может выступать не только в роли пассивного барьера, но и активно синтезироваться в ходе иммунных реакций. Это еще один способ его применения. Антропоцентричный читатель может возразить: «Грибы, насекомые, растения — это все примитивно. А у человека меланин только и нужен, чтобы защищать кожу от солнца». Как бы не так.
Нейромеланин
Мозг
Не весь меланин в организме человека производится специализированными клетками кожи. Нейромеланин синтезируется в нейронах.
В мозге человека (и некоторых других приматов, хотя и в меньшей степени) обнаруживаются участки, окрашенные в черный цвет. В основном эти участки расположены в среднем мозге (черная субстанция) и мосте (голубое пятно [25]), и немного — в продолговатом мозге (рис. 16). Нейроны обоих участков — катехоламинэргические, в черной субстанции они синтезируют дофамин, а в голубом пятне — норадреналин. Считается, что именно эти вещества и являются прекурсорами для синтеза меланина [26].

Рисунок 16. Участки мозга человека, в которых синтезируется нейромеланин. В мозге человека три основных участка содержат клетки, синтезирующие нейромеланин: (а) — черная субстанция в среднем мозге, (б) голубое пятно в мосте и (в) — вентролатеральная ретикулярная формация и ядро одиночного пути в продолговатом мозге. Только (а) и (б) содержат крупные кластеры темных пигментированных нейронов, которые можно увидеть на макропрепаратах.
При рождении нейромеланина в мозге нет — он накапливается по мере взросления, особенно активно в подростковом возрасте. При некоторых нейродегенеративных заболеваниях, например, болезни Паркинсона, окрашенные районы мозга бледнеют. Это происходит из-за аутоиммунной реакции, вызывающей гибель меланизированных нейронов [27].
Можно решить, что нейромеланин — всего лишь побочный продукт метаболизма катехоламиновых нейромедиаторов, и в мозге у него нет никакой особой функции. Однако это, вероятно, не так.
Нейромеланин, как губка, поглощает опасные для мозга токсины, таким образом оберегая его от повреждения. Например, меланин способен связывать пестициды, токсичные металлы (железо, цинк, медь, марганец, хром, кобальт, ртуть, свинец и кадмий) и свободные радикалы, которые неизбежно появляются в ходе активного метаболизма [26].
Запас прочности у нейромеланина высокий, но он не бесконечен. Когда концентрация токсичных веществ превышает некоторый порог, меланин из антиоксиданта становится прооксидантом и начинает усиливать окисление. Окислительное повреждение ведет к смерти нейрона и высвобождению нейромеланина со всеми связанными с ним токсинами в ткани мозга. Это может приводить к воспалению мозга, которое наблюдается при развитии многих нейродегенеративных заболеваний [28].
Клетки нервного гребня
Чем нейромеланин отличается от обычного меланина кожи или волос? Прежде всего — происхождением клеток, которые его синтезируют.
Нейроны (и пигментный эпителий сетчатки глаза) происходят из нейроэпителия, т.е. из нервной трубки. А меланоциты кожи и других органов — из нервного гребня (рис. 17) [29], [30].

Рисунок 17. Схема последнего этапа формирования нервного гребня. После замыкания нервной трубки клетки ее верхней части обособляются, формируя нервный гребень. Затем эти клетки мигрируют по всему телу зародыша, давая начало множеству важнейших структур.
Клетки нервного гребня — это уникальная популяция клеток. После дифференциации нервного гребня от дорсальной стороны они начинают мигрировать к периферическим тканям развивающегося животного. Нервный гребень стал одним из самых важных «изобретений» хордовых животных, иногда его даже называют четвертым зародышевым листком (наряду с экто-, эндо- и мезодермой) [31].
Мультипотентные клетки нервного гребня способны давать начало самым разным клеточным типам, в том числе меланоцитам. Они колонизируют дерму и эпидермис кожи, волосяные фолликулы, а также участки внутреннего уха и строму радужки глаза, определяя цвет глаз [31].
Меланин и зрение
Среди широкого спектра животных, начиная со стрекающих (полипы и медузы), в состав фотосенсорных органов обязательно входит меланин. Он необходим для поглощения «лишнего» света, обеспечивая корректную работу фоторецепторов. У некоторых организмов меланин содержится прямо в фоторецепторах [31].
В более сложном типе глаз [32], как, например, у человека, меланин содержат клетки специального слоя сетчатки — пигментного эпителия (рис. 18) [33].

Рисунок 18. Гистологический препарат сетчатки и собственно сосудистой оболочки глаза (хориоидеа). Обозначены основные слои сетчатки.
Клетки пигментного эпителия сетчатки (ПЭС), вероятно, произошли от древних фотосенсорных клеток. Так, клетки ПЭС до сих пор, помимо синтеза меланина, участвуют в цикле преобразования ретинола — предшественника родопсина — и синтезируют некоторые неканонические опсины (светочувствительные белки). А у саламандр в случае травмы сетчатки клетки ПЭС способны откатывать назад свое развитие и участвовать в ее восстановлении. В том числе они могут стать полноценными фотосенсорными клетками [31].
Общее происхождение
Меланоциты очень похожи на клетки пигментного эпителия: они тоже продуцируют меланин, но не обладают способностью к фоторецепции. Или обладают?
На самом деле, меланоциты способны к производству собственных опсинов. Наглядный пример их работы — быстрое изменение окраски у водных существ. Меланоциты воспринимают падающий на них свет и перераспределяют внутри себя гранулы меланина, подстраивая цвет покровов животного под окружающую среду. Это не то же самое, что загар. Такое изменение окраски происходит гораздо быстрее, ведь меланоциты реагируют не на накопленный эффект излучения, а воспринимают его напрямую [31].
Вероятно, меланоциты кожи, так же, как и клетки ПЭС, произошли от древних фотосенсорных клеток хордовых животных. В процессе своего развития они «сбежали» от нервной системы и перестали снабжать ее зрительной информацией. Вместо этого они приобрели новые функции — камуфляж, фотопротекцию и обеспечение видимой окраски [31].
Итого…
Итак, меланин, несомненно, играет важную роль в приспособлении организмов к окружающей среде. Он защищает их от повреждающего излучения, связывает токсины и свободные радикалы, обеспечивает механическую прочность покровов. Многие организмы приспособили его под более сложные задачи — извлечение пользы из радиации, обеспечение иммунного ответа или зрение. Все благодаря относительно простому синтезу, который способна осуществить даже бактерия, и в то же время сложной структуре, слаженно работающей даже в экстремальных условиях. Меланин неразрывно связан с эволюцией жизни, и, возможно, подарит нам еще много полезных изобретений. Например, эффективный адсорбент тяжелых металлов для очищения окружающей среды; эко-френдли упаковку для продуктов, продлевающую срок их хранения, или биосовместимый переносчик для направленной доставки лекарств [34], [35].
Литература
- F. Solano. (2014). Melanins: Skin Pigments and Much More—Types, Structural Models, Biological Functions, and Formation Routes. New Journal of Science. 2014, 1-28;
- Department of Chemical Engineering and Biotechnology, MANIT, Bhopal (M.P.) - 462051, Sudha Singh, Anvita Gupta Malhotra, Ajay Pandey, Khushhali M Pandey. (2013). Computational model for pathway reconstruction to unravel the evolutionary significance of melanin synthesis. Bioinformation. 9, 94-100;
- Liliana D’Alba, Matthew D. Shawkey. (2019). Melanosomes: Biogenesis, Properties, and Evolution of an Ancient Organelle. Physiological Reviews. 99, 1-19;
- Maher Al Khatib, Mohamed Harir, Jessica Costa, Maria Camilla Baratto, Irene Schiavo, et. al.. (2018). Spectroscopic Characterization of Natural Melanin from a Streptomyces cyaneofuscatus Strain and Comparison with Melanin Enzymatically Synthesized by Tyrosinase and Laccase. Molecules. 23, 1916;
- Wen Song, Haoyue Yang, Song Liu, Huahua Yu, Dan Li, et. al.. (2023). Melanin: insights into structure, analysis, and biological activities for future development. J. Mater. Chem. B. 11, 7528-7543;
- Shosuke Ito. (2006). Encapsulation of a reactive core in neuromelanin. Proc. Natl. Acad. Sci. U.S.A.. 103, 14647-14648;
- Anh N. Tran-Ly, Carolina Reyes, Francis W. M. R. Schwarze, Javier Ribera. (2020). Microbial production of melanin and its various applications. World J Microbiol Biotechnol. 36;
- Raffaella Micillo, Lucia Panzella, Mariagrazia Iacomino, Giacomo Prampolini, Ivo Cacelli, et. al.. (2017). Eumelanin broadband absorption develops from aggregation-modulated chromophore interactions under structural and redox control. Sci Rep. 7;
- Paul Meredith, Tadeusz Sarna. (2006). The physical and chemical properties of eumelanin. Pigment Cell Research. 19, 572-594;
- Sepideh Soltani, Shahin Sowlati-Hashjin, Conrard Giresse Tetsassi Feugmo, Mikko Karttunen. (2022). Free Energy and Stacking of Eumelanin Nanoaggregates. J. Phys. Chem. B. 126, 1805-1818;
- Francisco Solano. (2020). Photoprotection and Skin Pigmentation: Melanin-Related Molecules and Some Other New Agents Obtained from Natural Sources. Molecules. 25, 1537;
- Agnes Mbonyiryivuze, Z. Y. Nuru, Balla Diop Ngom, Bonex Mwakikunga, Simon Mokhotjwa Dhlamini, et. al.. (2015). Morphological and Chemical Composition Characterization of Commercial Sepia Melanin. AJN. 3, 22-27;
- Aleksandra Ilina, Karen E. Thorn, Paul A. Hume, Isabella Wagner, Ronnie R. Tamming, et. al.. (2022). The photoprotection mechanism in the black–brown pigment eumelanin. Proc. Natl. Acad. Sci. U.S.A.. 119;
- Rana Khan, Banat Gul, Shamim Khan, Hasan Nisar, Iftikhar Ahmad. (2021). Refractive index of biological tissues: Review, measurement techniques, and applications. Photodiagnosis and Photodynamic Therapy. 33, 102192;
- Nawal Madkhali, Hadi. R Alqahtani, Seham Al-Terary, Amel Laref, Adel Hassib. (2019). Control of optical absorption and fluorescence spectroscopies of natural melanin at different solution concentrations. Opt Quant Electron. 51;
- Ekaterina Dadachova, Arturo Casadevall. (2008). Ionizing radiation: how fungi cope, adapt, and exploit with the help of melanin. Current Opinion in Microbiology. 11, 525-531;
- Arturo Casadevall, Radames J. B. Cordero, Ruth Bryan, Joshua Nosanchuk, Ekaterina Dadachova. (2017). Melanin, Radiation, and Energy Transduction in Fungi. Microbiol Spectr. 5;
- Ekaterina Dadachova, Ruth A. Bryan, Robertha C. Howell, Andrew D. Schweitzer, Philip Aisen, et. al.. (2008). The radioprotective properties of fungal melanin are a function of its chemical composition, stable radical presence and spatial arrangement. Pigment Cell Melanoma Res. 21, 192-199;
- Joshua D. Nosanchuk, Arturo Casadevall. (2003). The contribution of melanin to microbial pathogenesis. Cellular Microbiology. 5, 203-223;
- Rosanna P. Baker, Amy Z. Liu, Arturo Casadevall. (2024). Cell wall melanin impedes growth of the Cryptococcus neoformans polysaccharide capsule by sequestering calcium. Proc. Natl. Acad. Sci. U.S.A.. 121;
- Miranda M. A. Whitten, Christopher J. Coates. (2017). Re‐evaluation of insect melanogenesis research: Views from the dark side. Pigment Cell Melanoma Res. 30, 386-401;
- Daniel F. Q. Smith, Quigly Dragotakes, Madhura Kulkarni, J. Marie Hardwick, Arturo Casadevall. (2022). Galleria mellonella immune melanization is fungicidal during infection. Commun Biol. 5;
- Anastasiia Y. Glagoleva, Olesya Y. Shoeva, Elena K. Khlestkina. (2020). Melanin Pigment in Plants: Current Knowledge and Future Perspectives. Front. Plant Sci.. 11;
- Hui Zou, Qian Xiao, Guoce Li, Xiaoyu Wei, Xiaocheng Tian, et. al.. (2025). Revisiting the advancements in plant polyphenol oxidases research.. Scientia Horticulturae. 341, 113960;
- Тайны голубого пятна;
- H FEDOROW, F TRIBL, G HALLIDAY, M GERLACH, P RIEDERER, K DOUBLE. (2005). Neuromelanin in human dopamine neurons: Comparison with peripheral melanins and relevance to Parkinson's disease. Progress in Neurobiology. 75, 109-124;
- RobertL Haining, Cindy Achat-Mendes. (2017). Neuromelanin, one of the most overlooked molecules in modern medicine, is not a spectator. Neural Regen Res. 12, 372;
- Alexandra Moreno-García, Alejandra Kun, Miguel Calero, Olga Calero. (2021). The Neuromelanin Paradox and Its Dual Role in Oxidative Stress and Neurodegeneration. Antioxidants. 10, 124;
- Жизнь и путешествия замечательных клеток нервного гребня;
- Yasuyuki Fujii, Ayano Hatori, Daichi Chikazu, Toru Ogasawara. (2023). Application of Dental Pulp Stem Cells for Bone and Neural Tissue Regeneration in Oral and Maxillofacial Region. Stem Cells International. 2023, 1-11;
- Yuliia Fatieieva, Rozalina Galimullina, Sergey Isaev, Alexander Klimovich, Laurence A. Lemaire, Igor Adameyko. (2025). Melanocytes and photosensory organs share a common ancestry that illuminates the origins of the neural crest. Commun Biol. 8;
- Особенности механизмов зрения птиц;
- Suet Ding, Suresh Kumar, Pooi Mok. (2017). Cellular Reparative Mechanisms of Mesenchymal Stem Cells for Retinal Diseases. IJMS. 18, 1406;
- Lili Guo, Wenya Li, Zhiyang Gu, Litong Wang, Lan Guo, et. al.. (2023). Recent Advances and Progress on Melanin: From Source to Application. IJMS. 24, 4360;
- Mariana Caldas, Ana Cláudia Santos, Rita Rebelo, Irina Pereira, Francisco Veiga, et. al.. (2020). Electro-responsive controlled drug delivery from melanin nanoparticles. International Journal of Pharmaceutics. 588, 119773.
Комментарии
Раньше здесь был блок с комментариями. Но потом сервис Disqus, на котором они работали и за который мы платили, перестал открываться из РФ.
Когда появится возможность, мы вернём комментарии уже на внутреннем движке, а чтобы это произошло быстрее —
Оставьте донат 💚












